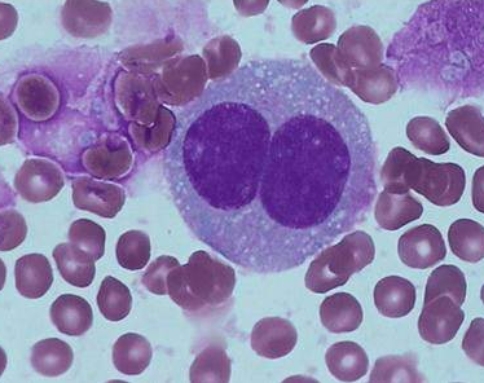
美国治疗淋巴瘤

PD-1抑制剂Opdivo联合靶向药Adcetris(brentuximab vedotin),治疗复发性或难治性(R/R)经典
霍奇金淋巴瘤(cHL),客观缓解率高达90%。这是制药公司百时美施贵宝(BMS)和武田(Takeda)近期公布的正在开展的I/II期临床研究的首批数据。
这些数据来自42例患者,其中29例可评估缓解。研究中,患者每3周接受一次Adcetris+Opdivo联合治疗,连续治疗4个周期。在完成第4个周期治疗后,患者有资格接受自体造血干细胞移植(ASCT)。该研究中,患者平均年龄37岁,大多数患者(88%)在接受标准一线治疗方案ABVD(阿霉素[adriamycin],博来霉素[bleomycin],长春新碱[vinblastine],氮烯咪胺[dacarbazine])后病情进展或复发。
Adcetris是一种靶向CD30蛋白的抗体-药物偶联物(ADC),CD30蛋白是经典霍奇金淋巴瘤(cHL)的明确生物标志物,在肿瘤生长和存活方面发挥重要作用。Opdivo是一种程序性死亡蛋白1(PD-1)免疫检查点抑制剂,旨在利用机体的免疫系统帮助恢复抗肿瘤免疫反应。将靶向治疗药物Adcetris与免疫系统激活治疗方法Opdivo联合用药是一种很有潜力的新治疗策略,两者具有协同作用,有望提高经典霍奇金淋巴瘤(cHL)的治效果果。
此次公布的初步结果令人信服,支持了这种无化疗组合方案的进一步临床探索。详细数据如下:
(1)可评估缓解的29例患者中,26例(90%)实现客观缓解,包括18例(62%)完全缓解和8例(28%)部分缓解;1例(3%)病情稳定,2例(7%)病情进展。
(2)入组的42例患者中,所有患者(满分)接受了一剂或多剂Adcetris+Opdivo治疗,12例(29%)仍在治疗,28例(67%)已完成治疗,2例(5%)在治疗结束前停止治疗。在数据分析时,9例(21%)启动自体造血干细胞移植(ASCT),2例在进行ASCT之前接受了一种替代抢救治疗。初步分析显示,Adcetris+Opdivo组合对干细胞动员(stem cell mobilization)和定植(engraftment)没有影响。
(3)该研究中,Adcetris+Opdivo组合的中位用药次数为4。42例患者中,无一例患者在治疗过程中因Adcetris或Opdivo的不良事件降低给药剂量。3例(7%)发生Adcetris给药延迟,4例(10%)发生Opdivo给药延迟。给药延迟的原因包括荨麻疹、血栓症、脂肪酶升高、寒颤和缺氧。
(4)不受威胁性方面,在接受ASCT前发生于超过20%的患者中的较常见不良事件包括疲劳、恶心、输注反应、瘙痒、皮疹。1例在接受第1个周期Adcetris之后发生治疗相关严重不良事件(3级脱水,1级乏力和恶心,2级高钙血症及不适)。
(5)输注相关反应(IRR)发生于38%的患者,较常见的症状包括:脸红和恶心(14%),胸闷、呼吸困难、荨麻疹(12%),咳嗽和瘙痒(分别为10%)。研究中进行了一次协议修订,术前进行低剂量糖皮质激素和抗组胺药治疗。无一例患者因IRR停止治疗。
(6)潜在免疫相关不良事件包括:IRR(36%,1级或2级),皮疹(29%,1级或2级),腹泻(26%,1级或2级),转氨酶升高(10%,1级和3/4级),甲状腺功能减退症(5%,2级)。未发生肺炎或肠炎。
目前,百时美和武田也正在开展另一项I/II期临床研究,调查Adcetris+Opdivo组合治疗方法治疗非霍奇金淋巴瘤(NHL)的潜力,包括弥漫性大B细胞淋巴癌(DLBCL)及其他罕见亚型的B细胞淋巴瘤(如纵隔B细胞淋巴瘤,纵隔灰区淋巴瘤)。除此之外,双方在较近已启动了一项临床研究,在霍奇金淋巴瘤(HL)老年群体中调查Adcetris+Opdivo组合一线治疗的潜力。
这项I/II期临床研究的首批数据,是在2016年底在美国圣地亚哥举行的第58届美国血液病学会(ASH)年会上公布的。
厚朴方舟2012年进入海外医疗领域,总部位于北京,建立了由全球权威医学专家组成的美日名医集团,初个拥有日本政府官方颁发的海外医疗资格的企业。如果您有海外就医的需要,请拨打免费热线进行咨询!
本文由厚朴方舟编译,版权归厚朴方舟所有,转载或引用本网版权所有之内容须注明"转自厚朴方舟官网(www.hopenoah.com)"字样,对不遵守本声明或其他违法、恶意使用本网内容者,本网保留追究其法律责任的权利。